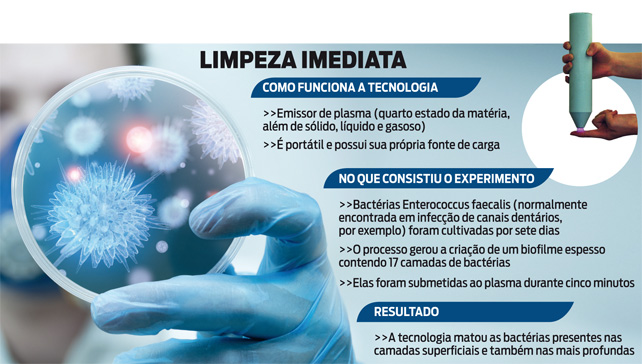

Um aparelho de plasma pequeno, portátil, que tem sua própria fonte de energia. Essa é a nova arma contra bactérias presentes na pele, capazes de provocar sérias infecções. Criada por pesquisadores australianos, a novidade foi apresentada em um artigo publicado na última edição do Journal of Physics D: Applied Physics. O equipamento foi apontado como uma ótima alternativa para ser usada em ambulâncias, no tratamento de feridos em desastres naturais ou em locais remotos – circunstâncias nas quais em geral não há acesso a recursos eficientes e fáceis de ser transportados.
Nos testes feitos em laboratório, a tecnologia conseguiu eliminar as bactérias Enterococcus faecalis (comum nas infecções de canais dentários, por exemplo) que compunham um biofilme espesso. Havia 17 camadas com os micro-organismos, mas apenas cinco minutos de exposição ao plasma foram suficientes para exterminá-los. “Na pesquisa, usamos um exemplo extremo para demonstrar que o aparelho pode ser efetivo”, explicou Kostya Ostrikov, coordenador da experiência. “Para um menor número de bactérias, a inativação pode ocorrer em questão de segundos”, complementou.
Ainda não se sabe ao certo o mecanismo pelo qual o plasma (o quarto estado da matéria) possui este efeito contra bactérias – e também contra os vírus. Uma das hipóteses é de que ele criaria reações similares às que ocorrem no sistema imunológico. Os cientistas estão animados também com o baixo preço do aparelho. “Ele pode ser fabricado a um custo de US$ 100”, diz Ostrikov.
